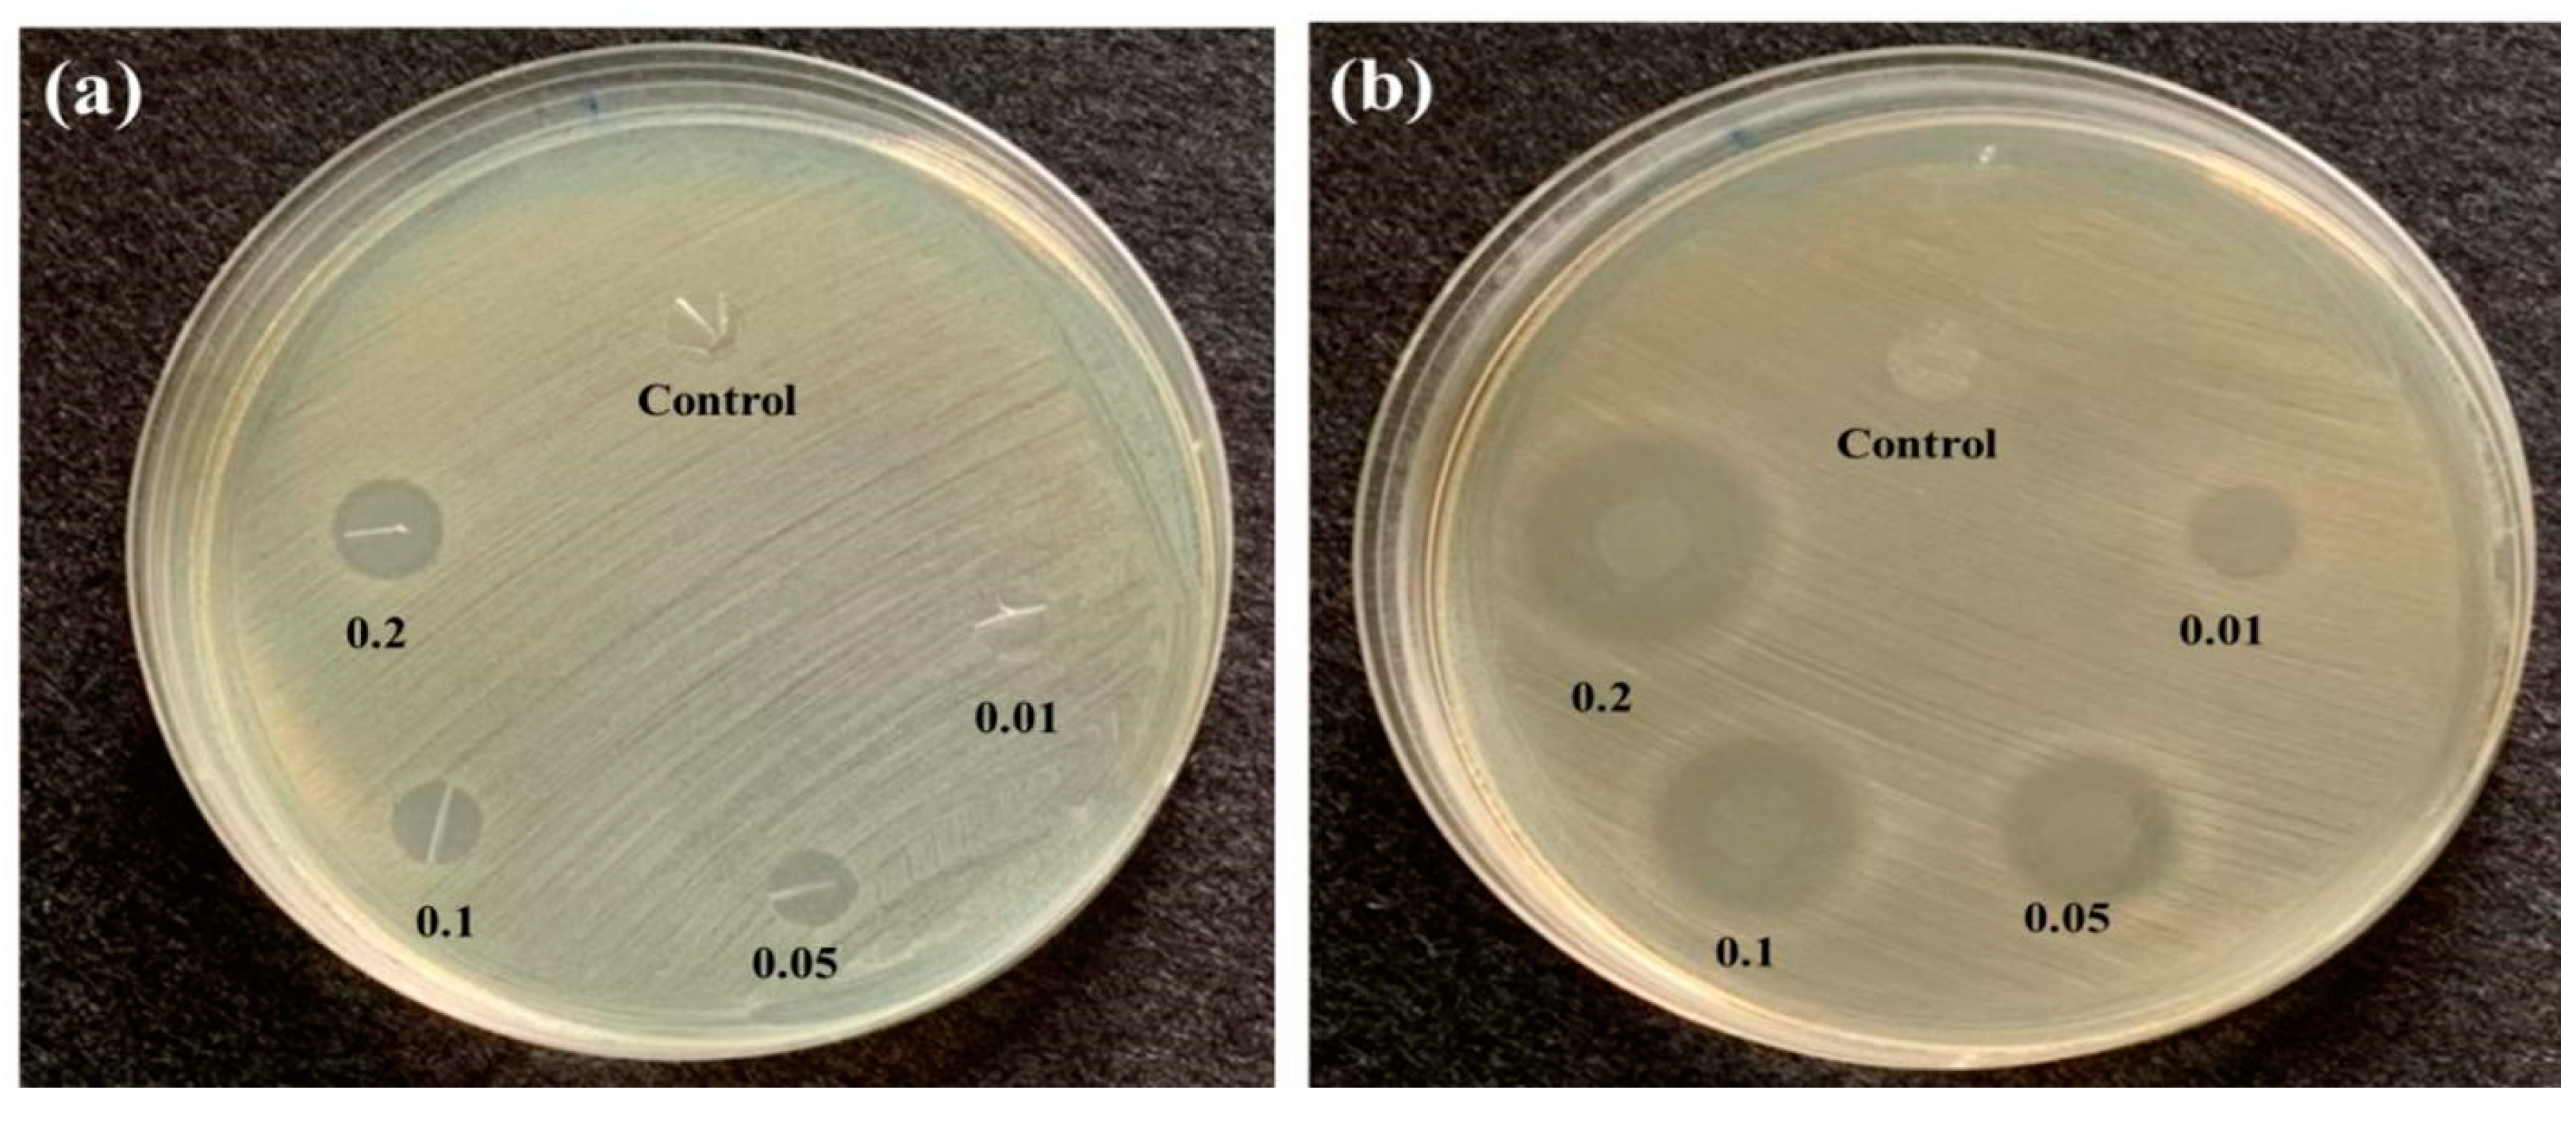
Polymers 14 02514 g008 550

A Study on Preparation and Property Evaluations of Composites Consisting of TPU/Triclosan Membranes and Tencel®/LMPET Nonwoven Fabrics
Abstract
:1. Introduction
2. Materials and Methods
2.1. Materials
2.2. Preparation of Tencel®/LMPET Nonwoven Fabrics
2.3. Preparation of Tencel®/LMPET/TPU Matrices for Antibacterial Membranes
2.4. Characterizations
3. Results and Discussion
3.1. Tearing Strength and Stiffness of Tencel®/LMPET Nonwoven Fabrics
3.2. Air Permeability of Tencel®/LMPET Nonwoven Fabrics
3.3. Bursting Strength of Tencel®/LMPET/TPU/Triclosan Composites
3.4. SEM Observation of Tencel®/LMPET/TPU/Triclosan Composites
3.5. Antibacterial Efficacy of Tencel®/LMPET/TPU/Triclosan Composites
3.6. Stiffness and Water Resistance of Tencel®/LMPET/TPU/Triclosan Composites
4. Conclusions
Author Contributions
Funding
Institutional Review Board Statement
Informed Consent Statement
Data Availability Statement
Conflicts of Interest
References
- Jiang, X.; Bai, Y.; Chen, X.; Liu, W. A review on raw materials, commercial production and properties of lyocell fiber. J. Bioresour. Bioprod. 2020, 5, 16–25. [Google Scholar] [CrossRef]
- Perepelkin, K.E. Lyocell fibres based on direct dissolution of cellulose in N-methylmorpholine N-oxide: Development and prospects. Fibre Chem. 2007, 39, 163–172. [Google Scholar] [CrossRef]
- Zhang, S.; Chen, C.; Duan, C.; Hu, H.; Li, H.; Li, J.; Liu, Y.; Ma, X.; Stavik, J.; Ni, Y. Regenerated cellulose by the Lyocell process, a brief review of the process and properties. BioResources 2018, 13, 4577–4592. [Google Scholar] [CrossRef]
- Wang, S.; Lu, A.; Zhang, L. Recent advances in regenerated cellulose materials. Prog. Polym. Sci. 2016, 53, 169–206. [Google Scholar] [CrossRef]
- Shen, L.; Worrell, E.; Patel, M.K. Environmental impact assessment of man-made cellulose fibres. Resour. Conserv. Recycl. 2010, 55, 260–274. [Google Scholar] [CrossRef]
- Basit, A.; Latif, W.; Baig, S.A.; Afzal, A. The Mechanical and Comfort Properties of Sustainable Blended Fabrics of Bamboo with Cotton and Regenerated Fibers. Cloth. Text. Res. J. 2018, 36, 267–280. [Google Scholar] [CrossRef]
- Asmiza, N.A.N.; Nasir, S.H. A Review on Mechanical and Comfort Properties of Medical Bandages from Different Material and Finishing. Prog. Eng. Appl. Technol. 2021, 2, 904–911. [Google Scholar]
- Kim, H.-A. Moisture Vapor Permeability and Thermal Wear Comfort of Ecofriendly Fiber-Embedded Woven Fabrics for High-Performance Clothing. Materials 2021, 14, 6205. [Google Scholar] [CrossRef]
- Lin, J.-H.; Hsu, P.-W.; Huang, C.-H.; Lai, M.-F.; Shiu, B.-C.; Lou, C.-W. A Study on Carbon Fiber Composites with Low-Melting-Point Polyester Nonwoven Fabric Reinforcement: A Highly Effective Electromagnetic Wave Shield Textile Material. Polymers 2022, 14, 1181. [Google Scholar] [CrossRef] [PubMed]
- Pang, K.; Kotek, R.; Tonelli, A. Review of conventional and novel polymerization processes for polyesters. Prog. Polym. Sci. 2006, 31, 1009–1037. [Google Scholar] [CrossRef]
- Patti, A.; Cicala, G.; Acierno, D. Eco-sustainability of the Textile Production: Waste Recovery and Current Recycling in the Composites World. Polymers 2020, 13, 134. [Google Scholar] [CrossRef]
- Hsieh, J.-C.; Li, J.-H.; Huang, C.-H.; Lou, C.-W.; Lin, J.-H. Statistical analyses for tensile properties of nonwoven geotextiles at different ambient environmental temperatures. J. Ind. Text. 2017, 47, 331–347. [Google Scholar] [CrossRef]
- Douka, A.; Vouyiouka, S.; Papaspyridi, L.-M.; Papaspyrides, C.D. A review on enzymatic polymerization to produce polycondensation polymers: The case of aliphatic polyesters, polyamides and polyesteramides. Prog. Polym. Sci. 2018, 79, 1–25. [Google Scholar] [CrossRef]
- Kucuk, M.; Korkmaz, Y. Sound absorption properties of bilayered nonwoven composites. Fibers Polym. 2015, 16, 941–948. [Google Scholar] [CrossRef]
- Majumdar, A.; Shukla, S.; Singh, A.A.; Arora, S. Circular fashion: Properties of fabrics made from mechanically recycled poly-ethylene terephthalate (PET) bottles. Resour. Conserv. Recycl. 2020, 161, 104915. [Google Scholar] [CrossRef]
- Pudack, C.; Stepanski, M.; Fässler, P. PET Recycling—Contributions of Crystallization to Sustainability. Chem. Ing. Tech. 2020, 92, 452–458. [Google Scholar] [CrossRef] [Green Version]
- Welle, F. Twenty years of PET bottle to bottle recycling—An overview. Resour. Conserv. Recycl. 2011, 55, 865–875. [Google Scholar] [CrossRef]
- Jiang, J.; Liu, F.; Yang, X.; Xiong, Z.; Liu, H.; Xu, D.; Zhai, W. Evolution of ordered structure of TPU in high-elastic state and their influences on the autoclave foaming of TPU and inter-bead bonding of expanded TPU beads. Polymer 2021, 228, 123872. [Google Scholar] [CrossRef]
- Yao, Y.; Xiao, M.; Liu, W. A Short Review on Self-Healing Thermoplastic Polyurethanes. Macromol. Chem. Phys. 2021, 222, 2100002. [Google Scholar] [CrossRef]
- Boubakri, A.; Haddar, N.; Elleuch, K.; Bienvenu, Y. Impact of aging conditions on mechanical properties of thermoplastic polyurethane. Mater. Des. 2010, 31, 4194–4201. [Google Scholar] [CrossRef]
- Pattanayak, A.; Jana, S.C. Properties of bulk-polymerized thermoplastic polyurethane nanocomposites. Polymer 2005, 46, 3394–3406. [Google Scholar] [CrossRef]
- El-Shekeil, Y.A.; Sapuan, S.M.; Abdan, K.; Zainudin, E.S. Influence of fiber content on the mechanical and thermal properties of Kenaf fiber reinforced thermoplastic polyurethane composites. Mater. Des. 2012, 40, 299–303. [Google Scholar] [CrossRef]
- Tan, J.; Ding, Y.M.; He, X.T.; Liu, Y.; An, Y.; Yang, W.M. Abrasion resistance of thermoplastic polyurethane materials blended with ethylene-propylene-diene monomer rubber. J. Appl. Polym. Sci. 2008, 110, 1851–1857. [Google Scholar] [CrossRef]
- Dimonie, D.; Coserea, R.M.; Singurel, G.; Zaharia, C.; Darie, R.N.; Pop, S.F. Rheological properties of polyvinyl chloride—Thermoplastic polyurethane blends. Mater. Plast. 2009, 46, 321–326. [Google Scholar]
- Parnell, S.; Min, K. Reactive blending of thermoplastic polyurethane in situ with poly(vinyl chloride). Polym. Eng. Sci. 2005, 45, 876–887. [Google Scholar] [CrossRef]
- Dann, A.B.; Hontela, A. Triclosan: Environmental exposure, toxicity and mechanisms of action. J. Appl. Toxicol. 2011, 31, 285–311. [Google Scholar] [CrossRef] [PubMed]
- Caswell, K.J.; Long, S.K. The expanding role of managed care in the Medicaid program: Implications for health care access, use, and expenditures for nonelderly adults. INQUIRY J. Health Care Organ. Provis. Financ. 2015, 52. [Google Scholar] [CrossRef] [Green Version]
- Montaseri, H.; Forbes, P.B. A review of monitoring methods for triclosan and its occurrence in aquatic environments. TrAC Trends Anal. Chem. 2016, 85, 221–231. [Google Scholar] [CrossRef] [Green Version]
- Li, M.; He, Y.; Sun, J.; Li, J.; Bai, J.; Zhang, C. Chronic Exposure to an Environmentally Relevant Triclosan Concentration Induces Persistent Triclosan Resistance but Reversible Antibiotic Tolerance in Escherichia coli. Environ. Sci. Technol. 2019, 53, 3277–3286. [Google Scholar] [CrossRef] [PubMed]
- Shrestha, P.; Zhang, Y.; Chen, W.-J.; Wong, T.-Y. Triclosan: Antimicrobial mechanisms, antibiotics interactions, clinical applications, and human health. J. Environ. Sci. Health C Toxicol. Carcinog. 2020, 38, 245–268. [Google Scholar] [CrossRef]
- Gavilanes-Martínez, M.A.; Coral-Garzón, A.; Cáceres, D.H.; García, A.M. Antifungal activity of boric acid, triclosan and zinc oxide against different clinically relevant Candida species. Mycoses 2021, 64, 1045–1052. [Google Scholar] [CrossRef] [PubMed]
- Sathishkumar, T.; Naveen, J.; Satheeshkumar, S. Hybrid fiber reinforced polymer composites—A review. J. Reinf. Plast. Compos. 2014, 33, 454–471. [Google Scholar] [CrossRef]
- Lou, C.W.; Wu, Z.H.; Lin, J.H. Processing Technique and Property Evaluations of Chitosan Dressings. Adv. Mater. Res. 2014, 910, 178–181. [Google Scholar] [CrossRef]
- Nguyen, T.-T.; Tran, D.-T.; Bui, T.-A. A Study on Designing a Machine for Testing the Resistance to Wet Bacterial Penetration of Medical Protective Clothing Based on the British Standard EN 14126: 2003. In Proceedings of the 2nd Annual International Conference on Material, Machines and Methods for Sustainable Development (MMMS2020), Nha Trang, Vietnam, 12–15 November 2020; Springer: Cham, Switzerland, 2020; pp. 731–737. [Google Scholar] [CrossRef]
- Laing, R.M. Protection Provided by Clothing and Textiles Against Potential Hazards in the Operating Theatre. Int. J. Occup. Saf. Ergon. 2008, 14, 107–115. [Google Scholar] [CrossRef] [PubMed]
- Kim, H.-A. Water Repellency/Proof/Vapor Permeability Characteristics of Coated and Laminated Breathable Fabrics for Outdoor Clothing. Coatings 2021, 12, 12. [Google Scholar] [CrossRef]
- Ahmed, T.; Ogulata, R.T.; Bozok, S.S. Silver nanoparticles against SARS-CoV-2 and its potential application in medical protective clothing—A review. J. Text. Inst. 2021, 1–14. [Google Scholar] [CrossRef]

| Triclosan Content (wt%) | E. coli | S. aureus |
|---|---|---|
| Inhibition Zone (mm) | ||
| Triclosan 0 | 0 | 0 |
| Triclosan 0.01 | 0.6 | 1.3 |
| Triclosan 0.05 | 1.0 | 3.4 |
| Triclosan 0.1 | 1.3 | 5.9 |
| Triclosan 0.2 | 2.0 | 7.4 |
| Standard Specification | Results of This Study | |
|---|---|---|
| Tensile strength | MD and CD ≥ 45 N | MD 53.2 N, CD 33.5 N |
| Bursting strength | ≥45 N | 83 N |
| Strong seam | ≥40 N | ----------------- |
| Tear strength | ≥20 N | 53.5 N |
| Moisture permeability | ≥2500 g/m2.24 h | 2350 g/m2.24 h |
| Hydrostatic pressure | ≥50 cm H2O | 537–549 cm/H2O |
| Grade penetration | ≥1 g | ----------------- |
| Microbial indicators | not checked | obvious inhibition zone |
Publisher’s Note: MDPI stays neutral with regard to jurisdictional claims in published maps and institutional affiliations. |
© 2022 by the authors. Licensee MDPI, Basel, Switzerland. This article is an open access article distributed under the terms and conditions of the Creative Commons Attribution (CC BY) license (https://creativecommons.org/licenses/by/4.0/).
Share and Cite
Shiu, B.-C.; Hsu, P.-W.; Lin, J.-H.; Chien, L.-F.; Lin, J.-H.; Lou, C.-W. A Study on Preparation and Property Evaluations of Composites Consisting of TPU/Triclosan Membranes and Tencel®/LMPET Nonwoven Fabrics. Polymers 2022, 14, 2514. https://doi.org/10.3390/polym14122514
Shiu B-C, Hsu P-W, Lin J-H, Chien L-F, Lin J-H, Lou C-W. A Study on Preparation and Property Evaluations of Composites Consisting of TPU/Triclosan Membranes and Tencel®/LMPET Nonwoven Fabrics. Polymers. 2022; 14(12):2514. https://doi.org/10.3390/polym14122514
Chicago/Turabian StyleShiu, Bing-Chiuan, Po-Wen Hsu, Jian-Hong Lin, Ling-Fang Chien, Jia-Horng Lin, and Ching-Wen Lou. 2022. "A Study on Preparation and Property Evaluations of Composites Consisting of TPU/Triclosan Membranes and Tencel®/LMPET Nonwoven Fabrics" Polymers 14, no. 12: 2514. https://doi.org/10.3390/polym14122514
APA StyleShiu, B.-C., Hsu, P.-W., Lin, J.-H., Chien, L.-F., Lin, J.-H., & Lou, C.-W. (2022). A Study on Preparation and Property Evaluations of Composites Consisting of TPU/Triclosan Membranes and Tencel®/LMPET Nonwoven Fabrics. Polymers, 14(12), 2514. https://doi.org/10.3390/polym14122514

